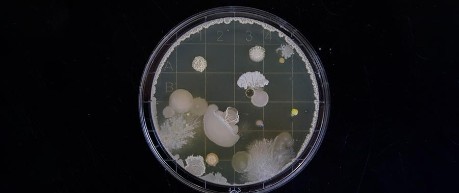
image of bacteria - credit University of Edinburgh

Tuesday 8th October 2019, 11:00am
Rising antimicrobial resistance, fuelled by overuse of treatments, could be curbed with a framework inspired by climate change targets.
Efforts to control the rise of antibiotic resistance could be informed by lessons learned from the climate change crisis, research suggests.
Over-use of antibiotics in medicine and agriculture, which leads to infections becoming resistant to treatment, could be remedied with the introduction of upper limits for industry sectors, according to scientists.
This approach would mirror the adoption of limits in greenhouse gas emissions in different countries.
Curbing the use of drugs where this might have minimal impact, such as their routine addition to livestock feeds, could make a significant difference in restricting the growth of resistance, according to research from the University of Edinburgh�s Global Academy of Agriculture and Food Security.
Their suggested framework could help meet a need identified by the UN Interagency Coordination Group (IACG) on global AMR governance for global efforts to assess and develop policy solutions for management of antimicrobial resistance.
Measures are urgently needed to limit the spread of antimicrobial resistance, whereby infections develop genes that can resist treatment and make therapies ineffective.
The latest research, published in BMJ Global Health, seeks to address the lack of a common framework to tackle the rise of antimicrobial resistance.
It offers a systematic approach to collect data on antibiotic use across medical, animal and agricultural sectors, to inform the creation of realistic reduction targets.
This could identify and prioritise the most effective interventions to modify use of antibiotics across all settings, informing policy decisions.
The research was supported by the Economic and Social Research Council.
"The current challenge with antimicrobial resistance resembles where we were 20 years ago with climate change. We can use lessons learned from that to form a collective approach to shape our response, limit spread of resistance and enable continued effective use of antibiotics."
Dominic Moran, Professor of Agriculture and Resource Economics, Global Academy of Agriculture and Food Security.